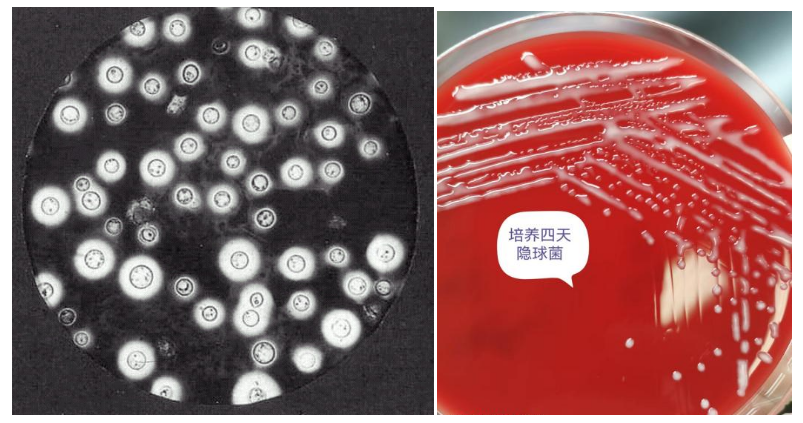

隐球菌感染(尤其是新型隐球菌Cryptococcus neoformans和格特隐球菌C. gattii)是威胁免疫抑制患者生命的重要机会性感染,常见于HIV/AIDS、器官移植、长期使用糖皮质激素及肿瘤化疗患者,主要侵犯肺、脑及脑膜,有时也侵犯皮肤、骨和关节等。其中,隐球菌性脑膜炎致死率高,早期诊断是改善预后的关键。
随着免疫抑制剂、抗癌药物、广谱抗生素的使用,机会性真菌感染的发病率也在逐渐上升,隐球菌病也越来越多地见于免疫功能正常的患者中,2022年隐球菌位列世界卫生组织(World Health Organization,WHO)公布的真菌重点病原体清单的榜首,在全球范围内对人类健康构成了严重威胁。
传统检测方法(如墨汁染色、真菌培养)存在灵敏度低、耗时长等局限性。为此,我院检验科引进隐球菌荚膜抗原胶体金法检测项目,为临床早期诊断隐球菌病提供快速、精准的病原学诊断支持。
一、胶体金法检测隐球菌荚膜多糖抗原的技术优势
1. 快速便捷:无需复杂设备,15-20分钟即可获得结果,突破传统培养需3-7天的瓶颈,为急重症患者争分夺秒。
2. 高灵敏度与特异性:胶体金法通过抗原-抗体特异性结合,可检测血清或脑脊液中低至0.5 ng/mL的微量荚膜多糖抗原,灵敏度达95%以上,特异性>98%。
3. 样本类型灵活:可检测脑脊液、血清、肺泡灌洗液等多种样本,满足不同部位感染的诊断需求。
4. 早期诊断能力:在感染早期即可检出抗原,优于依赖病原体增殖的传统方法。
二、适用人群
1. 免疫抑制患者(HIV、器官移植、糖尿病等)出现不明原因发热、头痛、意识障碍或肺部阴影等。
2. 疑似隐球菌性脑膜炎或播散性隐球菌病者。
3. 肺部结节或空洞性病变需排除感染性病因者。
三、隐球菌荚膜多糖抗原检测的临床诊断意义
1. 隐球菌性脑膜炎的鉴别诊断
隐球菌性脑膜炎常以头痛、发热、意识障碍起病,易与结核性脑膜炎、病毒性脑膜炎混淆。脑脊液墨汁染色阳性率仅30%-50%,而胶体金法抗原检测阳性率可达95%以上,显著减少漏诊。对于HIV阳性患者,抗原检测更是诊断隐球菌性脑膜炎的“金标准”。
2. 肺隐球菌病的精准筛查
肺隐球菌病临床表现不典型,影像学多表现为结节或团块影,易误诊为肺癌或肺结核。血清或肺泡灌洗液荚膜多糖抗原检测可快速区分感染性质,避免不必要的侵入性检查(如肺穿刺活检)。
3.其他隐球菌病的诊断
其他隐球菌病包括皮肤黏膜隐球菌病、骨隐球菌病及内脏隐球菌病,多数情况下作为播散型隐球菌病的一种表现,与脑、肺等部位隐球菌病同时存在,一般不作为独立疾病进行诊断。当怀疑有隐球菌病时,血清隐球菌荚膜抗原检测阳性被列为隐球菌病的重要免疫学证据。
胶体金法检测隐球菌荚膜多糖抗原为隐球菌感染提供了高效、可靠的诊断工具,尤其对隐球菌性脑膜炎和肺隐球菌病的早期识别至关重要。通过推广该技术、提高临床送检意识,可显著缩短诊断时间、改善患者预后。检验科将持续优化检测流程,为临床提供精准支持,共同守护患者生命健康。
我们呼吁:对于疑似隐球菌感染病例,尤其是免疫功能低下患者,请优先送检隐球菌荚膜多糖抗原检测,早诊断、早治疗,降低死亡率!
——以精准检验赋能临床,以创新技术守护健康。
(供稿:检验科)